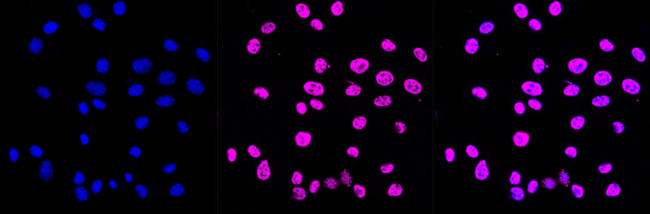
Phospho-C-Jun/D-Jun (Ser73, Ser100) Antibody in Immunocytochemistry (ICC/IF)

Search
Invitrogen
Phospho-C-Jun/D-Jun (Ser73, Ser100) Recombinant Rabbit Monoclonal Antibody (23GB4495)
{{$productOrderCtrl.translations['antibody.pdp.commerceCard.promotion.promotions']}}
{{$productOrderCtrl.translations['antibody.pdp.commerceCard.promotion.viewpromo']}}
{{$productOrderCtrl.translations['antibody.pdp.commerceCard.promotion.promocode']}}: {{promo.promoCode}} {{promo.promoTitle}} {{promo.promoDescription}}. {{$productOrderCtrl.translations['antibody.pdp.commerceCard.promotion.learnmore']}}
图: 1 / 3
Phospho-C-Jun/D-Jun (Ser73, Ser100) Antibody (MA5-52704) in ICC/IF



Please note: We are reviewing Western blot images included in the antibody testing data in our catalog, including those provided by third parties. Unless expressly labeled or annotated as “raw-unedited”, Western blot images included in the antibody testing data in our catalog may have been edited, optimized or otherwise adjusted for presentation.
产品信息
MA5-52704
种属反应
宿主/亚型
Expression System
分类
类型
克隆号
抗原
偶联物
形式
浓度
规格
纯化类型
保存液
内含物
保存条件
运输条件
RRID
靶标信息
C-Jun/D-Jun are members of the MAP kinase family. MAP kinases act as an integration point for multiple biochemical signals, and are involved in a wide variety of cellular processes such as proliferation, differentiation, transcription regulation and development. This kinase is activated by various cell stimuli, and targets specific transcription factors, and thus mediates immediate-early gene expression in response to cell stimuli. The activation of this kinase by tumor-necrosis factor alpha (TNF-alpha) is found to be required for TNF-alpha induced apoptosis. This kinase is also involved in UV radiation induced apoptosis, which is thought to be related to cytochrom c-mediated cell death pathway. Studies of the mouse counterpart of this gene suggested that this kinase play a key role in T cell proliferation, apoptosis and differentiation. Several alternatively spliced transcript variants encoding distinct isoforms have been reported. [provided by RefSeq, Apr 2016]
仅用于科研。不用于诊断过程。未经明确授权不得转售。
篇参考文献 (0)
生物信息学
蛋白别名: Activator Protein 1; AH119; AP-1; AP1; Avian sarcoma virus 17 (v-jun) oncogene homolog; C-JUN; CJUN; Enhancer-Binding Protein AP1; immediate early; Jun A; Jun Activation Domain Binding Protein; Jun Oncogene; Jun proto-oncogene related gene d; Jun proto-oncogene related gene d1; Jun Proto-Oncogene, AP-1 Transcription Factor Subunit; JunD-FL isoform; P39; Proto-oncogene c-Jun; Proto-Oncogene CJun; Transcription Factor AP-1; Transcription Factor AP-1 Subunit Jun; Transcription factor AP-1 subunit JunD; Transcription Factor Jun; transcription factor jun-D; Transcription factor JunD; V-Jun Avian Sarcoma Virus 17 Oncogene Homolog; v-jun sarcoma virus 17 oncogene homolog
基因别名: AP-1; c-jun; JUN; Jun-d; Junc; JUND; Jund1; Rjg-9
UniProt ID: (Rat) P17325, (Mouse) P05627, (Rat) P52909, (Mouse) P15066
Entrez Gene ID: (Rat) 24516, (Mouse) 16476, (Rat) 24518, (Mouse) 16478